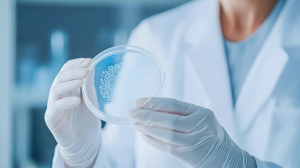

Darmanalysen
Darmanalysen (Mikrobiom) – der Darm und seine Bewohner!
Erkrankungen und Stressfaktoren beeinträchtigen die Situation im Darm. Eine veränderte Darmflora kann also ein erster Hinweis auf Störungen oder Erkrankungen sein.
Eine mikrobiologische Stuhlfloraanalyse liefert wertvolle Informationen über die Situation im Darm. Der Florastatus deckt Störungen des mikrobiellen Gleichgewichtes auf und erlaubt Rückschlüsse über die Abwehrsituation.
Wenn auch Sie über die Situation in Ihrem Darm informiert sein möchten, können wir einen Florastatus durchführen.
Sie erhalten Stuhlröhrchen inklusive Versandmaterial und Proben-Auffanghilfe von uns für zu Hause. Bitte beachten Sie, dass Sie die Probe von mehreren Stellen des Stuhls entnehmen und das Stuhlröhrchen bis zur Füllmarke füllen. Beschriften Sie bitte das Röhrchen mit Ihrem Namen und dem Entnahmedatum. Geben Sie die verpackte Probe am besten direkt beim Postamt ab.
Aufgaben der Darmflora:
- Beitrag zur Immunabwehr (Kolonisationsresitenz)
- Nährstoffversorgung der Dickdarmschleimhaut
- Anregung der Darmtätigkeit (Motilität)
- Bildung von Vitamin K
Das mikrobiologische Gleichgewicht wird gestört durch:
- Fehlernährung (viel Fett, Eiweiß)
- Medikamente (Abführmittel, Antibiotika, Corticoide)
- Erkrankungen im Verdauungstrakt, Infektionen
- Allergien, Unverträglichkeiten, Stress
Der Biovis-Florastatus gibt individuell Auskunft über:
- Die wichtigsten aeroben Bakterien
- Die wichtigsten anaeroben Bakterien
- Besiedlung von Hefen und Schimmelpilzen
- Mögliche krankmachende Eigenschaften
- (Pathogenität) vorhandener Pilze
- Säuregrad (pH-Wert) zur Beurteilung des Milieus
- Möglichkeiten zur Wiederherstellung des gesunden Gleichgewichtes
- Vorhandensein von akuten oder chronischen Darmentzündungen
- Vorhandensein von Dysplasien (sog. Krebs-Vorstufen, oder Krebszellen)
Sie erhalten von uns eine ausführliche Auswertung, eine individuelle Therapieempfehlung und natürlich Ernährungs-Tipps.
Darmanalysen in Rostock – individuell und persönlich
In unserer Privatpraxis in Rostock betrachten wir die Darmflora nicht isoliert, sondern immer im Zusammenhang mit Ihrer gesamten Gesundheit. Eine Mikrobiomanalyse liefert wertvolle Hinweise auf Stoffwechsel, Abwehrlage und entzündliche Prozesse. Gemeinsam besprechen wir die Ergebnisse ausführlich und entwickeln ein auf Sie zugeschnittenes Behandlungskonzept – von gezielten Ernährungsstrategien über Mikronährstoffe bis hin zu ganzheitlichen Therapien, die das Gleichgewicht im Darm nachhaltig unterstützen.
Präventions- und Longevity-Beratung – Dauer: 30 Minuten
Preis: z. B. 140,77 € (nach GOÄ)

Sie wünschen einen Termin?
Brauchen Sie eine professionelle ärztliche Begleitung oder individuelle Betreuung, egal in welcher Lebenslage? Haben Sie spezielle Gesundheitsfragen? Oder möchten Sie mit einem bestimmten Check up einfach „sichergehen“?
Interessante Links
Hier findest Du ein paar interessante Links! Viel Spaß auf unserer Website :)Kontakt:
Dr. med. Christine Teichert
Privatmedizin Rostock
Medical Wellness Therapiezentrum
(im Hotel Warnemünder Hof)
Stolteraer Weg 8
18119 Rostock
Tel.: 0381/ 543 0102
Email: info@privatmedizin-rostock.de
Facebook: Medical Wellness Therapiezentrum
Instagram: Privatmedizin_Rostock
Öffnungszeiten:
Termine nur nach vorheriger Vereinbarung (ohne Warteliste)
Telefonisch: 0381/ 543 0102
oder
Online: Klicken Sie bitte hier!